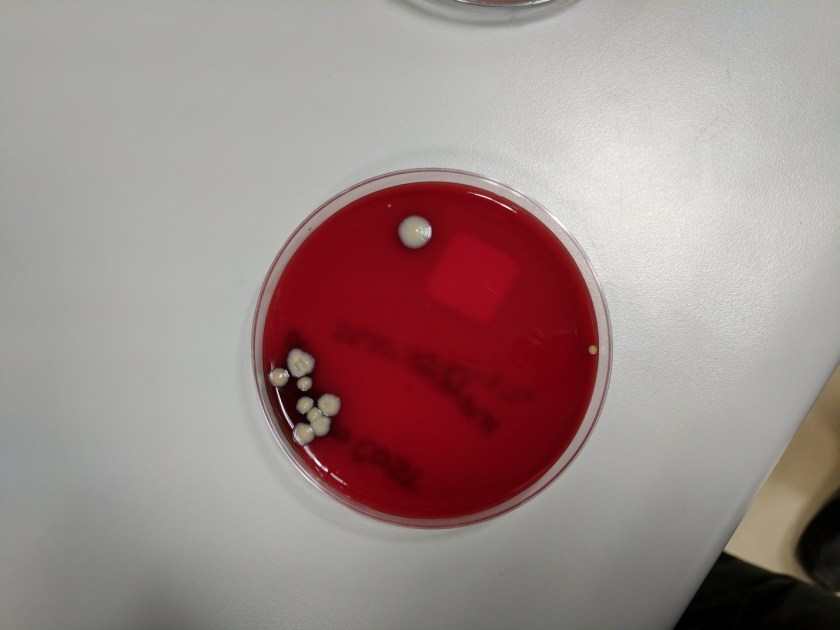
corstri1

Case History
A 65 year old male with a history of T7-8 paraplegia and lengthy history of a decubitus ulcer presented for surgical debridement of the wound. An ischial bone biopsy for culture was performed.
Lab Identification
The primary gram stain demonstrated mixed gram positive and gram negative organisms, and the tissue sample from the wound grew Corynebacterium striatum and Bacteroides fragilis. The bone sample grew Enterococcus faecalis and anaerobic gram positive cocci. He was initially treated with ertapenem alone but daptomycin was added to cover enterococcus and he continued this dual regimen. Daptomycin was discontinued due to elevated creatinine kinase levels and he was transitioned to intravenous vancomycin. He completed 42 days of ertapenem and vancomycin. He was transitioned to oral amoxicillin/clavulanic acid and he has not developed new fever, chills, sweats, fatigue or increased drainage from his wound.
Image 1. Blood agar plate with gray-white, moist, smooth, non-hemolytic bacterial colonies.

Image 2. Chocolate agar plate with gray-white, moist, smooth, bacterial colonies.
The blood and chocolate agar plates grew bacterial colonies while the MacConkey agar had no growth. The gram stain was consistent with Corynebacterium and mass spectrometry identified the organism as Corynebacterium striatum.
Discussion
Corynebacterium striatum is a gram positive bacilli that is part of normal skin and mucosal flora. In immunocompromised patients or through direct inoculation of a sterile site, C. striatum can cause infectious endocarditis, bacteremia, pneumonia, lung abscess, arthritis and chorioamnionitis. Studies have shown that C. striatum also can cause wound infections in patients with underlying disease and previous antibiotic use. Foreign medical devices can also be infected by C. striatum, and removal of the device may be necessary. Vancomycin is used to treat C. striatum due to the variable susceptibility to other antibiotics.
-Mustafa Mohammad, MD is a 3rd year anatomic and clinical pathology resident at the University of Vermont Medical Center.

-Christi Wojewoda, MD, is the Director of Clinical Microbiology at the University of Vermont Medical Center and an Assistant Professor at the University of Vermont.
Reblogged this on Not Your Average Microbiology Site.